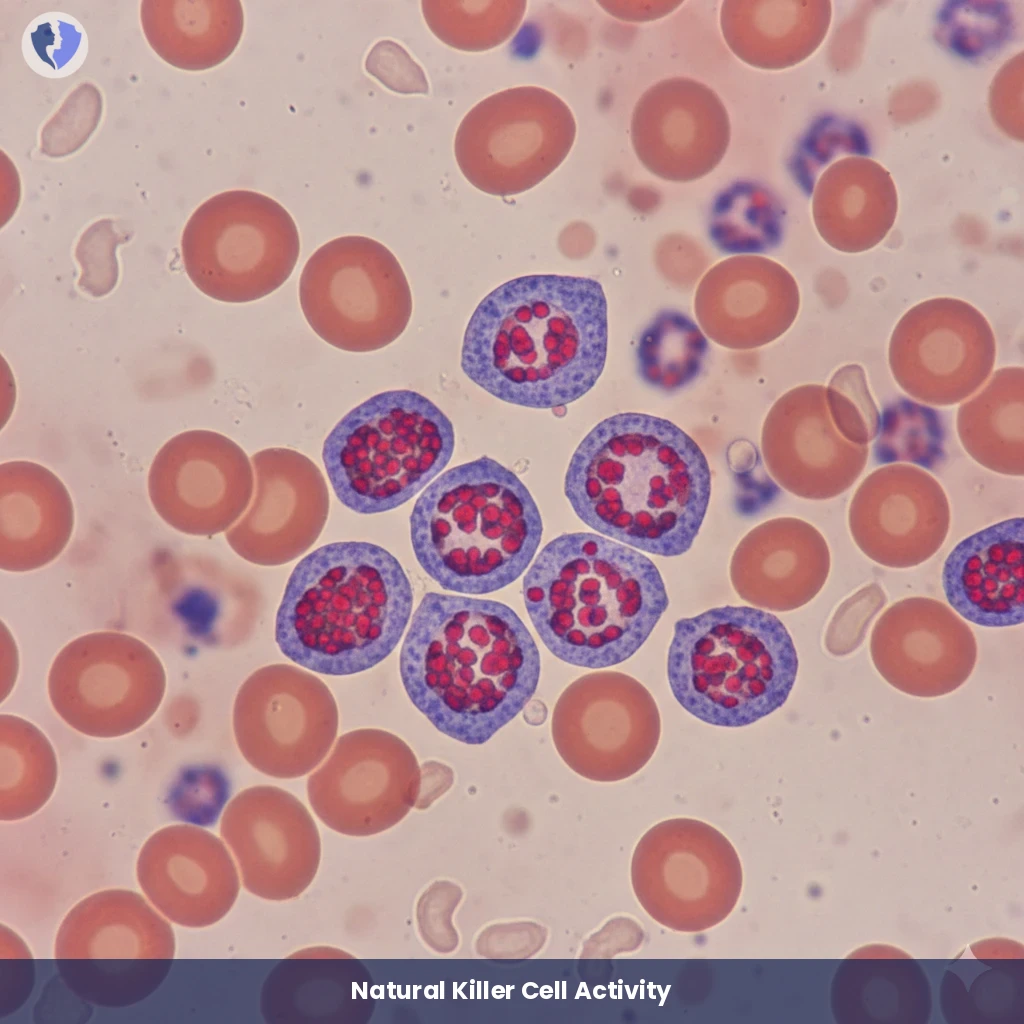
Natural Killer Cells Count - Natural Killer (NK) Cells Count (CD16/CD56)

Service Details
Natural Killer Cells Count - Natural Killer (NK) Cells Count (CD16/CD56)
Quantitative flow cytometry is used to enumerate and assess the activity of natural killer (NK) cells in peripheral blood. These cells express the surface markers CD16 and CD56 and represent a crucial primary line of innate immune defense against virus-infected and cancerous cells.